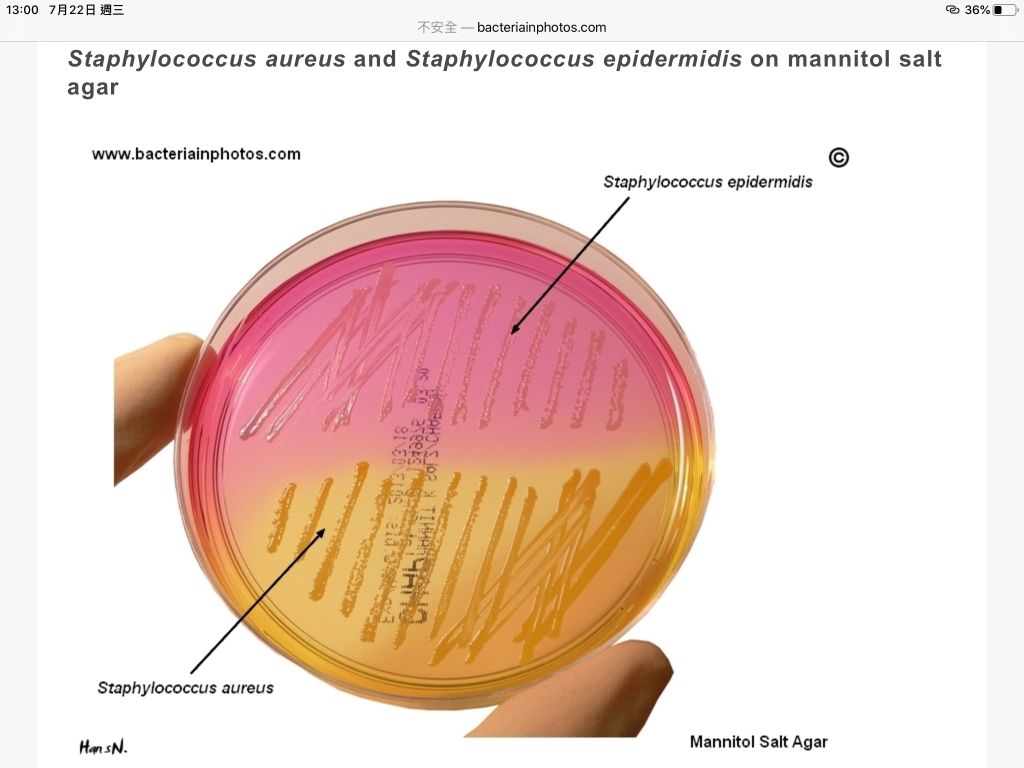

7.有關甘露醇鹽瓊脂(mannitol-salt agar)之敘述,下列何者錯誤?
(A)添加NaCl、mannitol及phenol red
(B)抑制革蘭氏陰性菌
(C)抑制葡萄球菌以外的革蘭氏陽性菌
(D)凝固酶陰性葡萄球菌皆可生長且發酵甘露醇
答案:登入後查看
統計: A(88), B(424), C(398), D(2085), E(0) #2183301
統計: A(88), B(424), C(398), D(2085), E(0) #2183301
詳解 (共 3 筆)
#3770960
mannitol salt agar 用來培養S aureus
有一題考古題提到做side時不取此agar上的菌來做怕有鹽干擾
S aureus 是Coagulase陽性菌 而且皆可生長跟發酵就很怪
64
0
#4164089
9
0